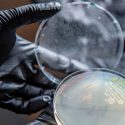

diseño
-

Inician en Mexico el diseño de vaginas por ingeniería de tejidos
Tres científicas mexicanas desarrollaron una técnica de ingeniería de tejidos para la construcción de vaginas en niñas que nacieron sin ellas. Hasta ahora, diez de…
-

Los drones podrán caminar sobre el agua con un nuevo diseño
Un nuevo modo de moverse saltando sobre superficies líquidas abre la puerta al diseño de futuros drones que puedan ‘caminar sobre el agua’. En colaboración…
-

Las alas de avión se reinventan con un diseño deformable
Un revolucionario diseño de ala de avión, ensamblada a partir de cientos de diminutas piezas idénticas, permite cambiar su forma para controlar el vuelo de…
-

Demuestran la viabilidad de los chips cuánticos a escala atómica en 3D
Científicos de la Universidad de Nueva Gales del Sur, en Sídney (Australia), han demostrado que su tecnología pionera puede adaptarse a la construcción de chips…
-

Un diseño inspirado en los pulmones convierte el agua en combustible
Científicos de la Universidad de Stanford han diseñado un mecanismo electrocatalítico que funciona como el pulmón de un mamífero para convertir el agua en combustible.…
-

Desde Japón, un mexicano revoluciona el diseño de trenes en diferentes países
Gracias a sus proyectos innovadores, el egresado de Ingeniería Industrial de la Universidad Iberoamericana (UIA), Daniel Rodríguez Escobar, mexicano, colabora en el diseño de trenes…